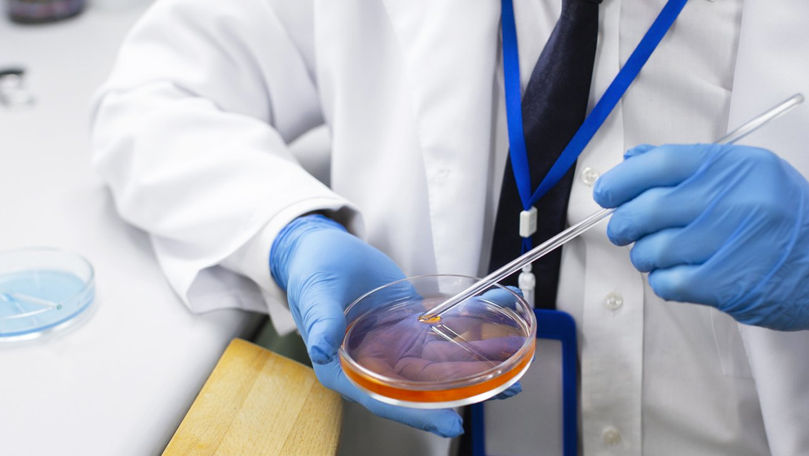
Ученые нашли способ «оживить» погибающие клетки.

Ученые нашли способ «оживить» погибающие клетки
Ученые из Базельского университета (Швейцария) установили, что пересадка здоровых «энергетических станций» — митохондрий в поврежденные клетки может повышать их выживаемость и восстанавливать энергетический обмен.
Основная функция митохондрий — производство АТФ, который является топливом для большинства клеточных процессов. Неправильная работа или повреждение митохондрий играют ключевую роль в процессах клеточной гибели, участвуя как в программируемой смерти (апоптозе), так и в неконтролируемой (некрозе), передает nature.com
В экспериментах на клеточных культурах, тканях человека и моделях мышей исследователи показали, что специально «направленные» митохондрии способны избирательно проникать в нужные клетки, включая нейроны и клетки сетчатки глаза, не распределяясь случайным образом по организму.
Ключевым достижением стала система молекулярной адресации: с ее помощью ученым удалось повысить эффективность доставки митохондрий к целевым клеткам примерно до 90%, тогда как без наведения этот показатель был значительно ниже. Попав внутрь, митохондрии сохраняли функциональность и начинали участвовать в выработке энергии.
В опытах на клетках пациентов с наследственными нарушениями зрения такая доставка повышала энергетическую активность клеток и увеличивала их выживаемость примерно на четверть при стрессовых воздействиях. Аналогичные результаты были получены и в тканях глаза человека, где наблюдалось улучшение работы поврежденных нейронов.
В экспериментах на мышах после травмы зрительного нерва пересадка митохондрий приводила к увеличению числа выживших нервных клеток и лучшему сохранению светочувствительных структур сетчатки по сравнению с контрольной группой.
По словам авторов, метод может стать основой будущей терапии нейродегенеративных и офтальмологических патологий. Однако исследователи подчеркивают, что пока речь идет о доклинических экспериментах, и для применения у людей необходимы дополнительные испытания на безопасность и эффективность.